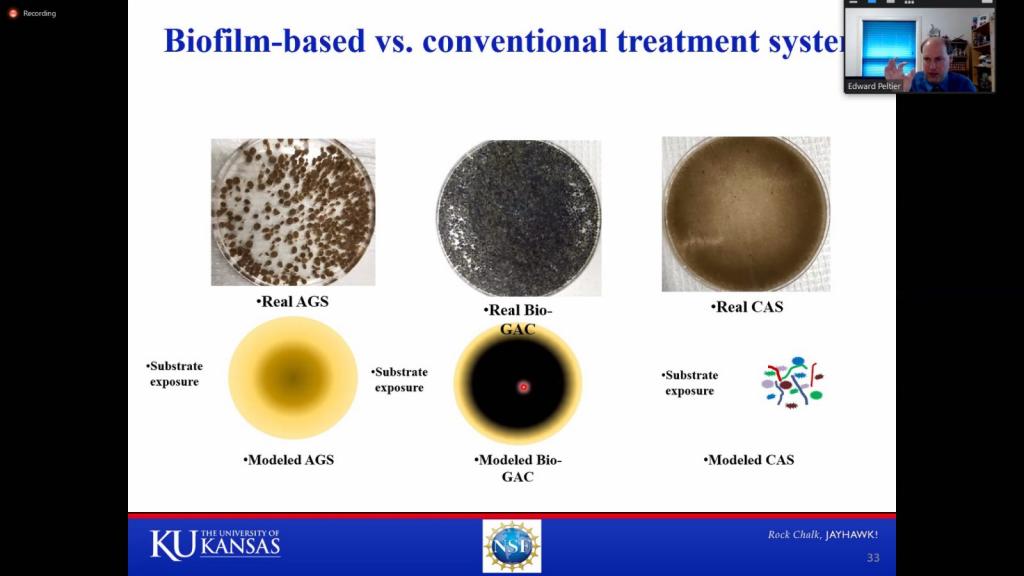

13 مايو، 2020
ورشة عمل في قسم هندسة البيئة

أقام قسم هندسة البيئة ورشة علمية إلكترونية بعنوان ( challenges one recovery and reuse of oil and gas produced water)
القاها الدكتور ايدوارد بلتير من جامعة كانساس – الولايات المتحدة الأمريكية وذلك في تمام الساعة التاسعة والنصف مساء من يوم الثلاثاء الموافق ل 12 أيار لسنة 2020